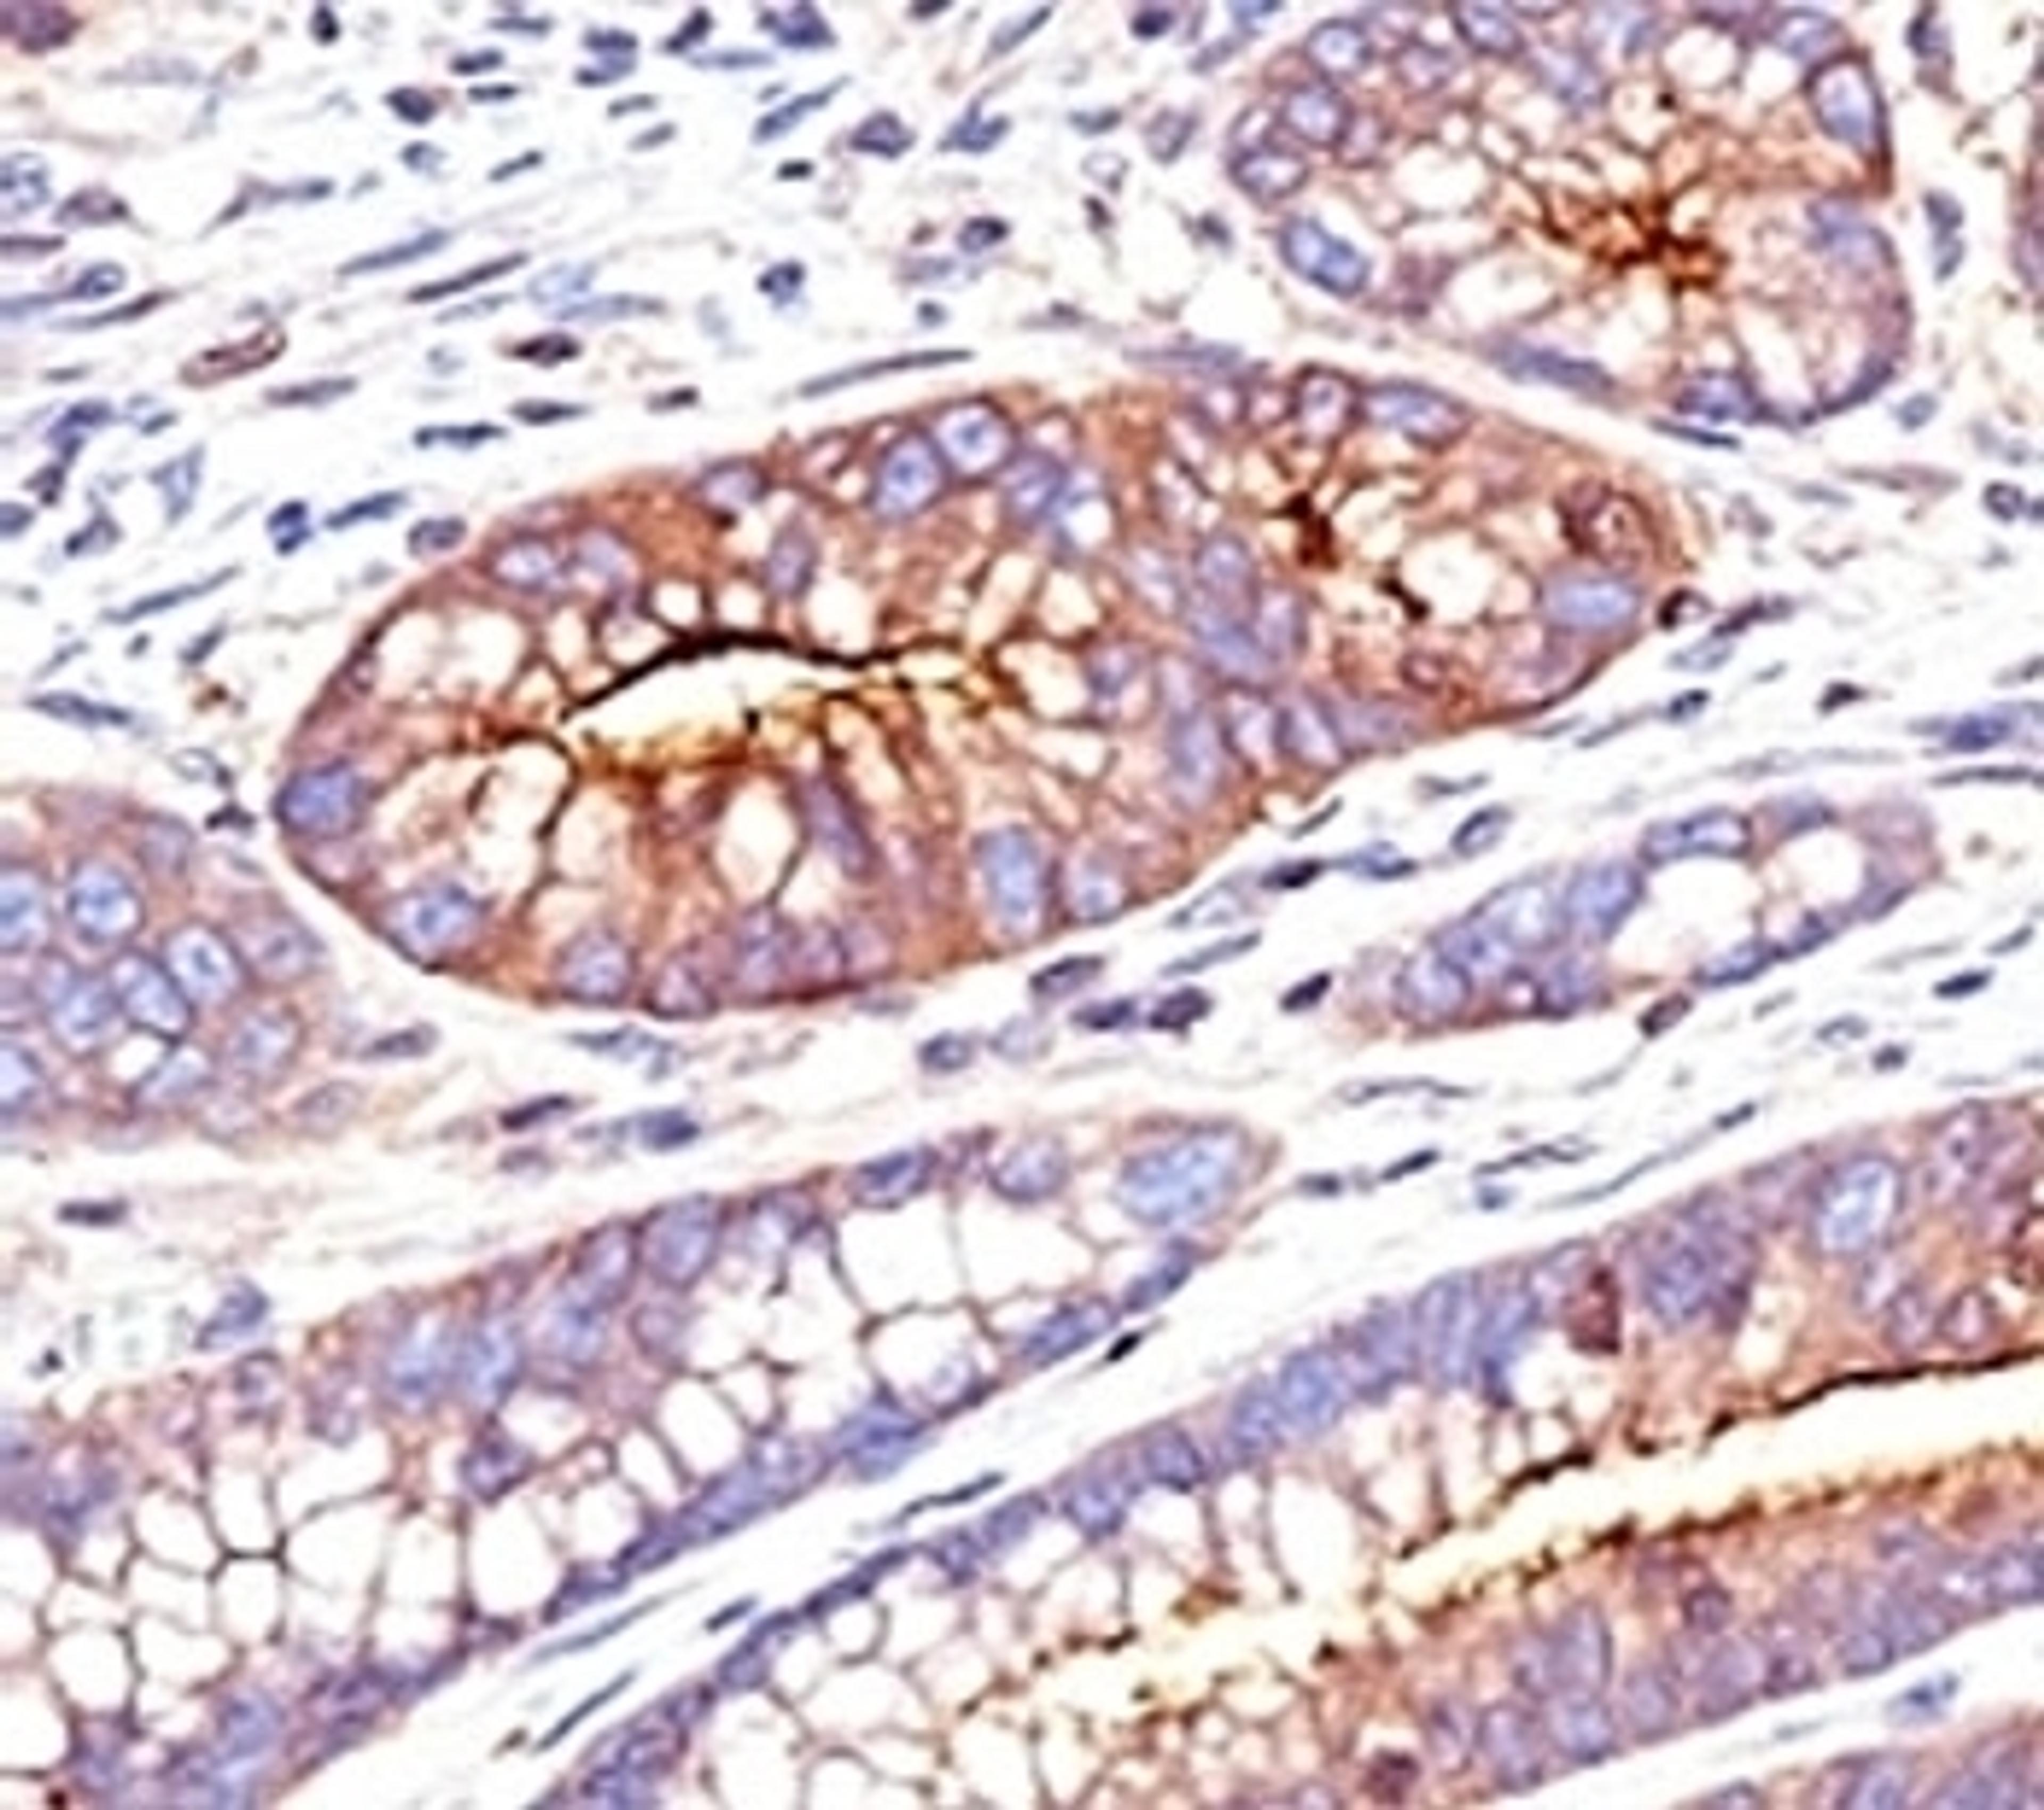
Formalin-fixed, paraffin-embedded human colon carcinoma stained with CEA antibody (SPM551)

Cadherin 16 Antibody [SPM594]
- Manufacturer
- Prosci Inc.
- Catalog Number
- 33-310
- Host
- Mouse
- Reactivity
- Dog (Canine), Human, Mouse, Rabbit (Lapine), Rat
- Applications
- Flow Cytometry, Immunofluorescence, Immunohistochemistry (Formalin-Fixed / Paraffin-Embedded Sections)